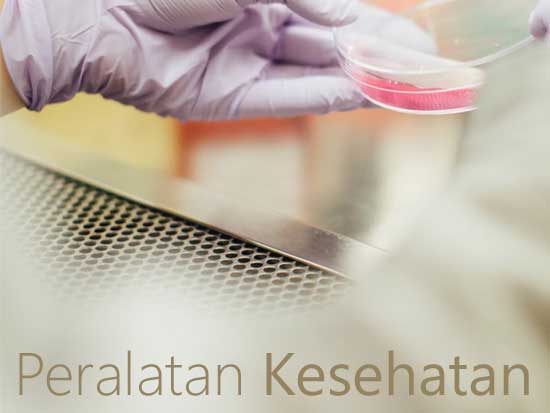

Peralatan kesehatan memegang peranan penting dalam dunia medis karena berkaitan langsung dengan keselamatan dan kenyamanan pasien. Untuk memastikan keandalan dan ketahanan, banyak peralatan kesehatan yang terbuat dari bahan stainless steel. Mengapa bahan ini dipilih secara luas dalam industri medis?

1. Ketahanan terhadap Korosi dan Karat
Stainless steel terkenal dengan ketahanannya terhadap korosi dan karat, yang sangat penting dalam dunia medis. Peralatan kesehatan, seperti alat bedah, alat medis lainnya, dan bahkan peralatan diagnostik, sering terpapar cairan tubuh, desinfektan, dan lingkungan yang lembap. Ketahanan stainless steel terhadap karat memastikan bahwa peralatan ini tidak hanya awet, tetapi juga aman digunakan dalam kondisi tersebut.
2. Kemudahan dalam Sterilisasi dan Kebersihan
Salah satu faktor utama dalam industri medis adalah kebersihan. Stainless steel memiliki permukaan yang halus dan mudah dibersihkan. Proses sterilisasi, baik menggunakan uap, gas, atau autoklaf, dapat dilakukan dengan efektif pada peralatan yang terbuat dari stainless steel. Bahan ini tidak akan terpengaruh oleh proses sterilisasi, sehingga peralatan medis tetap higienis dan bebas dari mikroorganisme berbahaya.
3. Kekuatan dan Daya Tahan Tinggi
Peralatan kesehatan membutuhkan bahan yang tidak hanya tahan lama tetapi juga kuat. Stainless steel memiliki daya tahan yang sangat tinggi, yang memungkinkan pembuatan peralatan dengan bentuk dan desain yang presisi, namun tetap kuat dan tahan lama. Alat bedah dan instrumen medis lainnya yang terbuat dari stainless steel dapat menahan tekanan dan penggunaan yang berat tanpa mengalami kerusakan.
4. Tidak Bereaksi dengan Obat-obatan dan Bahan Kimia
Di dunia medis, peralatan kesehatan seringkali terpapar pada berbagai jenis obat-obatan dan bahan kimia. Stainless steel memiliki sifat non-reaktif yang sangat penting, yang berarti tidak akan bereaksi dengan obat-obatan atau bahan kimia tersebut. Hal ini menghindarkan potensi kontaminasi atau perubahan kualitas obat atau bahan yang digunakan dalam prosedur medis.
5. Daya Tahan terhadap Suhu Ekstrem
Proses medis sering melibatkan suhu yang sangat tinggi atau sangat rendah, seperti dalam prosedur pemanasan atau pembekuan. Stainless steel memiliki ketahanan terhadap suhu ekstrem ini, sehingga dapat digunakan dalam berbagai aplikasi medis tanpa mengalami deformasi atau kerusakan.
6. Estetika dan Kesan Profesional
Selain fungsinya yang luar biasa, stainless steel juga memberikan kesan modern dan profesional. Banyak peralatan medis yang memiliki desain estetis, dan stainless steel memberi tampilan yang bersih, mengkilap, dan profesional. Ini juga berkontribusi pada persepsi positif pasien terhadap fasilitas medis yang mereka kunjungi.
7. Keamanan Pengguna dan Pasien
Peralatan kesehatan berbahan stainless steel tidak hanya aman bagi pasien, tetapi juga bagi tenaga medis yang menggunakannya. Bahan ini sangat sedikit kemungkinan mengandung bahan berbahaya seperti logam berat, yang dapat mempengaruhi kesehatan. Selain itu, stainless steel memiliki ketahanan terhadap gesekan dan tidak mudah pecah, yang mengurangi risiko cedera atau kecelakaan selama prosedur medis.
8. Ramah Lingkungan
Stainless steel adalah bahan yang dapat didaur ulang sepenuhnya. Mengingat pentingnya keberlanjutan dalam setiap sektor, termasuk medis, penggunaan stainless steel juga memiliki keuntungan dari segi ramah lingkungan. Setelah masa pakainya habis, bahan ini dapat didaur ulang tanpa kehilangan kualitasnya, mengurangi jumlah sampah medis yang berbahaya bagi lingkungan.
Kesimpulan
Peralatan kesehatan berbahan stainless steel menawarkan berbagai keunggulan, mulai dari ketahanan terhadap karat, kemudahan sterilisasi, hingga daya tahan yang tinggi. Selain itu, bahan ini juga aman, estetis, dan ramah lingkungan. Oleh karena itu, tidak heran jika stainless steel menjadi pilihan utama dalam pembuatan peralatan medis yang sangat bergantung pada kualitas, kebersihan, dan ketahanan. Pemilihan bahan yang tepat sangat penting untuk mendukung keselamatan pasien dan meningkatkan kualitas pelayanan kesehatan.
Dengan berbagai manfaat tersebut, jelas bahwa stainless steel merupakan pilihan ideal untuk peralatan kesehatan yang andal dan tahan lama. Yuk, Pesan di Nagamaro sekarang !
